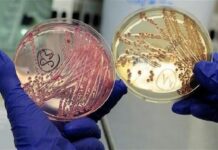

В Таджикистан поступила британская вакцина «AstraZeneca»
Для дальнейшего усиления работ по иммунизации граждан Таджикистана, в страну продолжает поступать вакцины от коронавирусной инфекции. По официальным данным Министерства здравоохранения и социальной защиты...
Вакцина от COVID-19 продолжает поступать в Таджикистан
В рамках механизма COVAX в Таджикистан поступила очередная партия вакцины против коронавируса «Pfizer-BioNTech». 3 апреля 2022 года в Таджикистан поступила партия вакцины «Pfizer-BioNTech» в...
Медучреждения Таджикистана обеспечат инсинераторами
Всемирная организация здравоохранения передала Таджикистану оборудование для утилизации медицинских отходов. 14 инсинераторов были переданы представителям Министерства здравоохранения и социальной защиты Республики Таджикистан 1 апреля...
В Таджикистане ревакцинацию от коронавируса прошли 19 процентов целевой группы
Минздрав Таджикистана сообщает, что в стране от коронавируса вакцинировано более 92 процента жителей. По официальным данным Министерства здравоохранения и социальной защиты населения Таджикистана, на...
Исфара. В приграничном селе открылся пункт скорой медицинской помощи (ФОТО)
Министерством здравоохранения и социальной защиты населения Таджикистана новому пункту передана автомашина скорой медицинской помощи. Как сообщил Зубайдулло Шоматов, пресс-секретарь председателя города Исфара, на церемонии открытия...
Всемирный банк предоставит Таджикистану дополнительные $25 млн на вакцинацию
14 марта 2022 года между Правительством Республики Таджикистан и Всемирным Банком подписано Соглашение о выделении гранта в размере 25 млн. долларов США в качестве...
Жители Согда могут пройти исследование по определению иммунитета к коронавирусу
С 14 по 19 марта 2022 года жители Согдийской области могут пройти исследование по определению иммунитета к вирусу COVID-19. Национальное исследование по определению иммунитета...
В больнице Пенджикента установили томограф
Впредь жители горных районов могут пройти томографию в центральной больнице города Пенджикент. Аппарат компьютерной томографии установлен в центральной больнице города Пенджикент Согдийской области. Об этом...
«Палочка Коха» унесла жизнь 26 согдийцев
В прошедшем году в Согдийской области зарегистрировано 774 новых случая инфицирования туберкулезом. В 2021 году на учете врачей состояли 2870 больных туберкулезом, из которых...
США восстанавливает аппарат по определения геномного секвенирования вируса COVID-19 в Таджикистане
Агентство США по международному развитию (USAID) восстанавливает единственный в Таджикистане аппарат секвенирования, специфичный для тестирования различных вариантов COVID-19. Аппарат по секвенированию будет введён в...